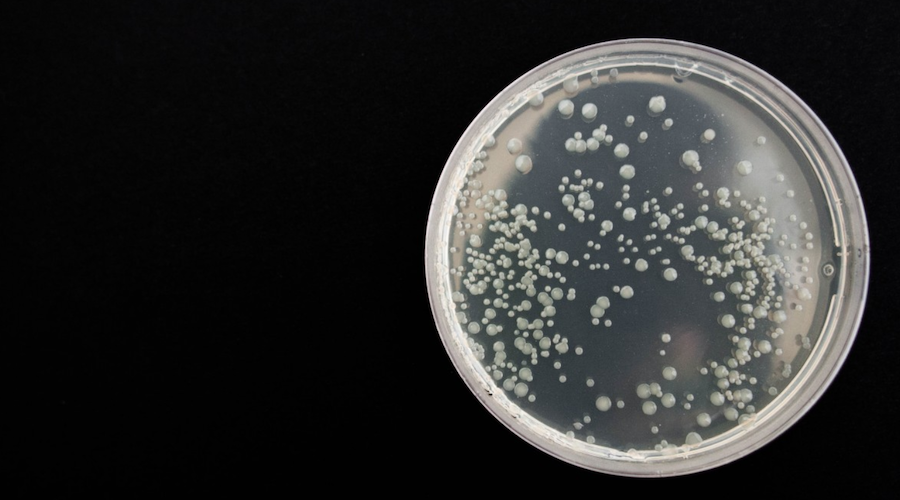
Scientists want to engineer bacteria to sustainability mine rare earths

Scientists want to engineer bacteria to sustainability mine rare earths
A new study published in Nature Communications describes a proof of principle for engineering a bacterium, Gluconobacter oxydans, that takes a first step towards meeting skyrocketing rare earth element demand in a way that matches the cost and efficiency of traditional thermochemical extraction and refinement methods and is clean enough to meet US environmental standards.
“We’re trying to come up with an environmentally friendly, low-temperature, low-pressure method for getting rare earth elements out of a rock,” Buz Barstow, the paper’s senior author and an assistant professor at Cornell University, said in a media statement.
To meet US annual needs for rare earth elements, roughly 71.5 million tonnes of raw ore would be required to extract 10,000 kilograms of elements.
Current methods rely on dissolving rock with hot sulphuric acid, followed by using organic solvents to separate very similar individual elements from each other in a solution.
“We want to figure out a way to make a bug that does that job better,” Barstow said.
G. oxydans is known for making an acid called biolixiviant that dissolves rock; the bacteria uses the acid to pull phosphates from rare earth elements. Thus, Barstow and his team have begun to manipulate G. oxydans‘ genes so it extracts the elements more efficiently.
To do so, the researchers used a technology called Knockout Sudoku, that allowed them to disable the 2,733 genes in G. oxydans‘ genome one by one. The team curated mutants, each with a specific gene knocked out, so they could identify which genes play roles in getting elements out of rock.
Lead author Alexa Schmitz, then identified genes involved in two systems in G. oxydans; one that puts the brakes on acidification and another that accelerates it.
“We believe that this mutant can’t tell when it’s had enough phosphate, so it keeps producing acidic biolixiviant to dissolve more,” Schmitz said.
The team is also working to find ways to regulate the gene that accelerates acid production. They hope to create a system where bacteria run on cheap cellulose-derived sugars for energy.
“I am incredibly optimistic,” Esteban Gazel, co-author of the article and associate professor of earth and atmospheric sciences, said. “We have a process here that is going to be more efficient than anything that was done before.”
In the study, Gazel’s lab helped develop mass spectrometry techniques, which Schmitz used to measure concentrations of rare earth elements from solutions where mutants were exposed to ore. “For some of the mutants, they were able to get very high concentrations [of rare earth elements from ore],” Gazel said.
More News
GRAPH: Cobalt price plunge and the EV market
February 11, 2025 | 04:03 pm
China funnelled $57 billion to control critical mineral supply chain
February 05, 2025 | 11:00 am
{{ commodity.name }}
{{ post.title }}
{{ post.date }}







Comments